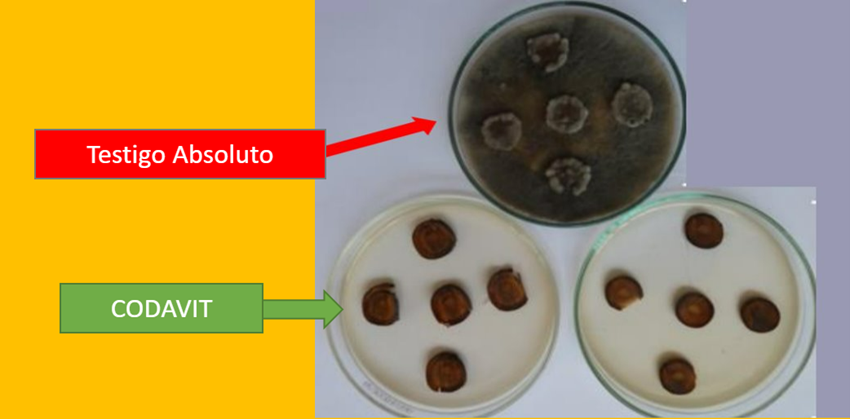

(Agraria.pe) El equipo técnico de AVIBIOL realizó un ensayo con Codavit para determinar el control de Lasiodiplodia theobromae en palto.
En el ensayo se consideró a un testigo absoluto, sulfato de cobre 5.H2O = 0.4 L/Cil (foliar), Codavit = 4 L/Ha (suelo) y extracto vegetal = 0.5 L/Cil (foliar).
En la metodología de evaluación se inocularon plantones de palto con conidias viables de Lasiodiplodia t. Luego de 7 días de la inoculación, se aplicaron los tratamientos orgánicos para determinar el control o avance del daño. El daño se representa en longitud (mm) de tejido afectado (necrosado) y este se evaluó hasta cuando el testigo tenía un avance significativo de necrosis en su tallo; esto fue a los 28 días después de la aplicación de los tratamientos.
Gráfico 1. Lesión causada por Lasiodiplodia t, en palto Hass. 
o resultado se obtuvo una lesión más pronunciada en el testigo absoluto por efecto de la inoculación, lo que indicaría que la inoculación fue eficiente. Por otro lado, los tratamientos lograron controlar cierto avance de la lesión. No obstante, el tratamiento CODAVIT obtuvo un crecimiento menor de la lesión, con solo 22 mm, indicando un mejor control de Lasiodiplodia.
EVALUACION DE TEJIDO AFECTADO EN PLACAS
Es así como, el tratamiento CODAVIT obtuvo un mejor control sobre el desarrollo de la lesión causada por Lasiodiplodia theobromae en plantas de palto, superando a los demás tratamientos.
Si quieres saber más sobre el ensayo y profundizar en la información puedes ingresar a este link: https://bit.ly/3Bwt4b0